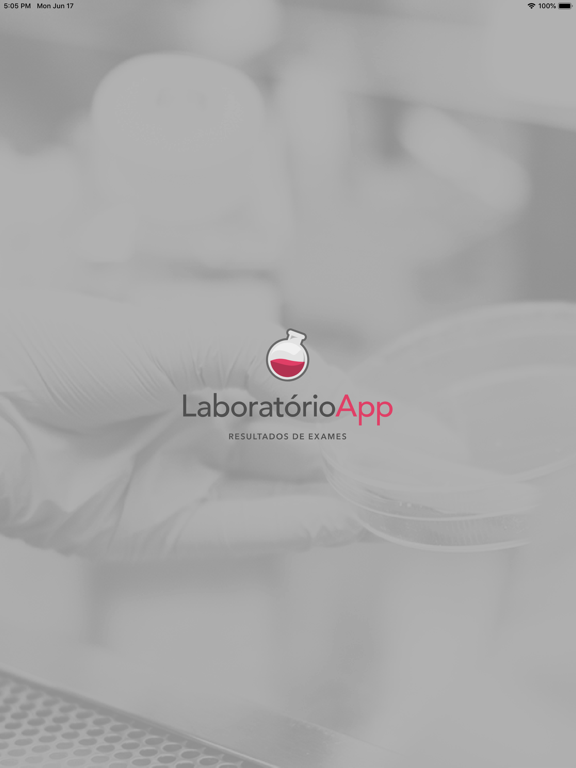
Screenshot #4 pour Laboratório App
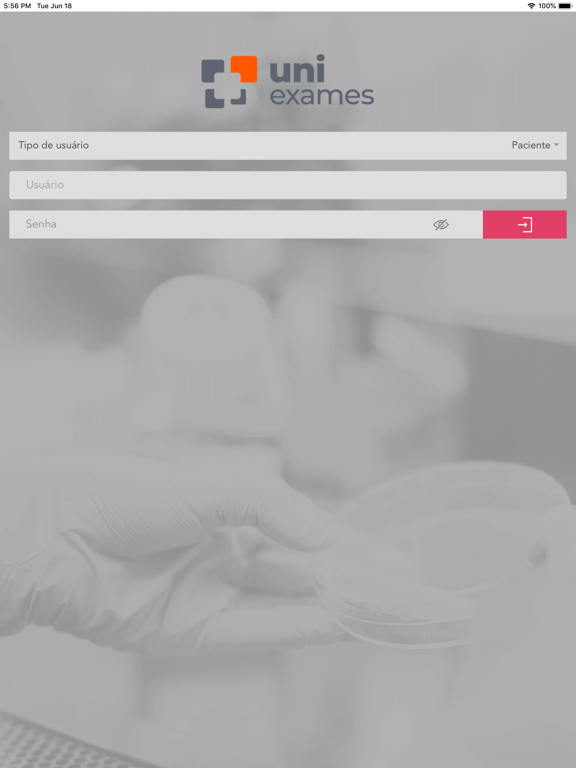
Screenshot #6 pour Laboratório App

Laboratório App
iOS Universel / Medecine
Este é um aplicativo para pacientes de laboratórios que utilizam o sistema Unilab. Ao baixá-lo você terá acesso a um formulário que o identificará como paciente ou administrador de laboratórios. Como paciente, você terá acesso aos seus laudos e poderá armazenar seus resultados no dispositivo (tablet ou smartphone). Como administrador, você terá acesso a diversas estatísticas, uma central de mensagens com a Uniware e acesso rápido a todos os novos recursos que a Uniware preparou para o seu laboratório.
En voir plus...
Quoi de neuf dans la dernière version ?
Nessa versão foi refeito a arquitetura do software, onde foi desenvolvido uma nova aplicação, salvando o usuário e a senha.